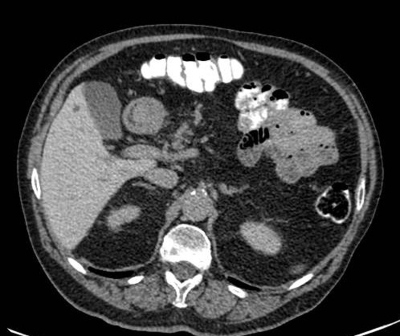

botones
Formatos para descargar
Visitas

revcolradiologia@gmail.com
Sonia Bermúdez Muñoz, Editora
Luz Angélica González Rodríguez, Asistente Editorial
Asociación Colombiana de Radiología
ISSN versión impresa: 0121-2095
ISSN versión en línea: 2590-714X